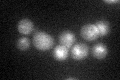
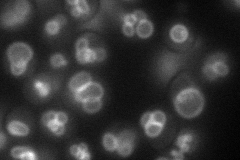
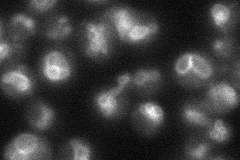
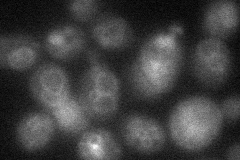
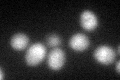

View description
Palmitoylated, vacuolar membrane-localized casein kinase I isoform; negatively regulates vacuole fusion during hypertonic stress via phosphorylation of Vps41p; shares essential functions with Hrr25p; regulates vesicle fusion in AP-3 pathway
Localization:
Intensity:
Fold change:
Significance:
-
C’ GFP library in SD
vacuole31.65 -
N' NOP1pr-GFP in SD
vacuole membrane59.0995 -
N' TEF2pr-mCherry in SD

vacuole membrane76.6577 -
N' NATIVEpr-GFP in SD
vacuole membrane40.2258 -
N' TEF2pr-VC and Cyto-VN in SD
vacuole membrane33.2444 -
C’ GFP library in SD+DTT
vacuole28.010.88No -
C’ GFP library in SD+H2O2

vacuole28.650.9No -
C’ GFP library in Starvation Media

vacuole41.411.3No -
C’ GFP library on the background of Pup2-DaMP

N/A -
C’ GFP library on the background of CCT mutant

N/A0N/AYes
